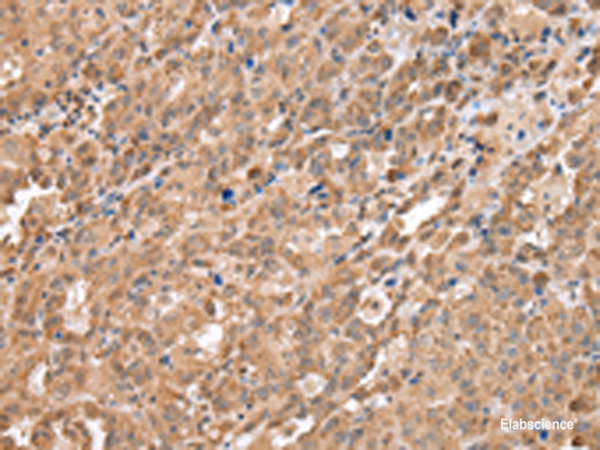
Anti-DDX58

Cookie preferences
This website uses cookies, which are necessary for the technical operation of the website and are always set. Other cookies, which increase the comfort when using this website, are used for direct advertising or to facilitate interaction with other websites and social networks, are only set with your consent.
Configuration
Technically required
These cookies are necessary for the basic functions of the shop.
"Allow all cookies" cookie
"Decline all cookies" cookie
CSRF token
Cookie preferences
Currency change
Customer-specific caching
FACT-Finder tracking
Individual prices
Selected shop
Session
Comfort functions
These cookies are used to make the shopping experience even more appealing, for example for the recognition of the visitor.
Note
Show the facebook fanpage in the right blod sidebar
Statistics & Tracking
Affiliate program
Conversion and usertracking via Google Tag Manager
Track device being used
If you have any questions, please use our Contact Form.
You can also order by e-mail: info@biomol.com
Larger quantity required? Request bulk
You can also order by e-mail: info@biomol.com
Larger quantity required? Request bulk
DEAD box proteins, characterized by the conserved motif Asp-Glu-Ala-Asp (DEAD), are putative RNA... more
Product information "Anti-DDX58"
DEAD box proteins, characterized by the conserved motif Asp-Glu-Ala-Asp (DEAD), are putative RNA helicases which are implicated in a number of cellular processes involving RNA binding and alteration of RNA secondary structure. This gene encodes a protein containing RNA helicase-DEAD box protein motifs and a caspase recruitment domain (CARD). It is involved in viral double-stranded (ds) RNA recognition and the regulation of immune response. Protein function: Innate immune receptor that senses cytoplasmic viral nucleic acids and activates a downstream signaling cascade leading to the production of type I interferons and proinflammatory cytokines. Forms a ribonucleoprotein complex with viral RNAs on which it homooligomerizes to form filaments. The homooligomerization allows the recruitment of RNF135 an E3 ubiquitin-protein ligase that activates and amplifies the RIG-I-mediated antiviral signaling in an RNA length-dependent manner through ubiquitination-dependent and -independent mechanisms (PubMed:28469175, PubMed:31006531). Upon activation, associates with mitochondria antiviral signaling protein (MAVS/IPS1) that activates the IKK-related kinases TBK1 and IKBKE which in turn phosphorylate the interferon regulatory factors IRF3 and IRF7, activating transcription of antiviral immunological genes including the IFN-alpha and IFN-beta interferons (PubMed:28469175, PubMed:31006531). Ligands include 5'- triphosphorylated ssRNAs and dsRNAs but also short dsRNAs (<1 kb in length). In addition to the 5'-triphosphate moiety, blunt-end base pairing at the 5'-end of the RNA is very essential. Overhangs at the non-triphosphorylated end of the dsRNA RNA have no major impact on its activity. A 3'overhang at the 5'triphosphate end decreases and any 5'overhang at the 5' triphosphate end abolishes its activity. Detects both positive and negative strand RNA viruses including members of the families Paramyxoviridae: Human respiratory syncytial virus and measles virus (MeV), Rhabdoviridae: vesicular stomatitis virus (VSV), Orthomyxoviridae: influenza A and B virus, Flaviviridae: Japanese encephalitis virus (JEV), hepatitis C virus (HCV), dengue virus (DENV) and west Nile virus (WNV). It also detects rotaviruses and reoviruses. Also involved in antiviral signaling in response to viruses containing a dsDNA genome such as Epstein-Barr virus (EBV). Detects dsRNA produced from non-self dsDNA by RNA polymerase III, such as Epstein-Barr virus- encoded RNAs (EBERs). May play important roles in granulocyte production and differentiation, bacterial phagocytosis and in the regulation of cell migration. [The UniProt Consortium]
| Keywords: | Anti-RLR-1, Anti-RIG-I, Anti-DDX58, Anti-RIG-1, EC=3.6.4.13, Anti-DEAD box protein 58, Anti-RIG-I-like receptor 1, Anti-Retinoic acid-inducible gene I protein, Anti-Retinoic acid-inducible gene 1 protein, Anti-Probable ATP-dependent RNA helicase DDX58, DD |
| Supplier: | Elabscience |
| Supplier-Nr: | E-AB-53369 |
Properties
| Application: | IHC, ELISA |
| Antibody Type: | Polyclonal |
| Conjugate: | No |
| Host: | Rabbit |
| Species reactivity: | human |
| Immunogen: | Synthetic peptide of human DDX58 |
Database Information
| KEGG ID : | K12646 | Matching products |
| UniProt ID : | O95786 | Matching products |
| Gene ID : | GeneID 23586 | Matching products |
Handling & Safety
| Storage: | -20°C |
| Shipping: | 4°C (International: -20°C) |
Caution
Our products are for laboratory research use only: Not for administration to humans!
Our products are for laboratory research use only: Not for administration to humans!
Information about the product reference will follow.
more
You will get a certificate here
Viewed




